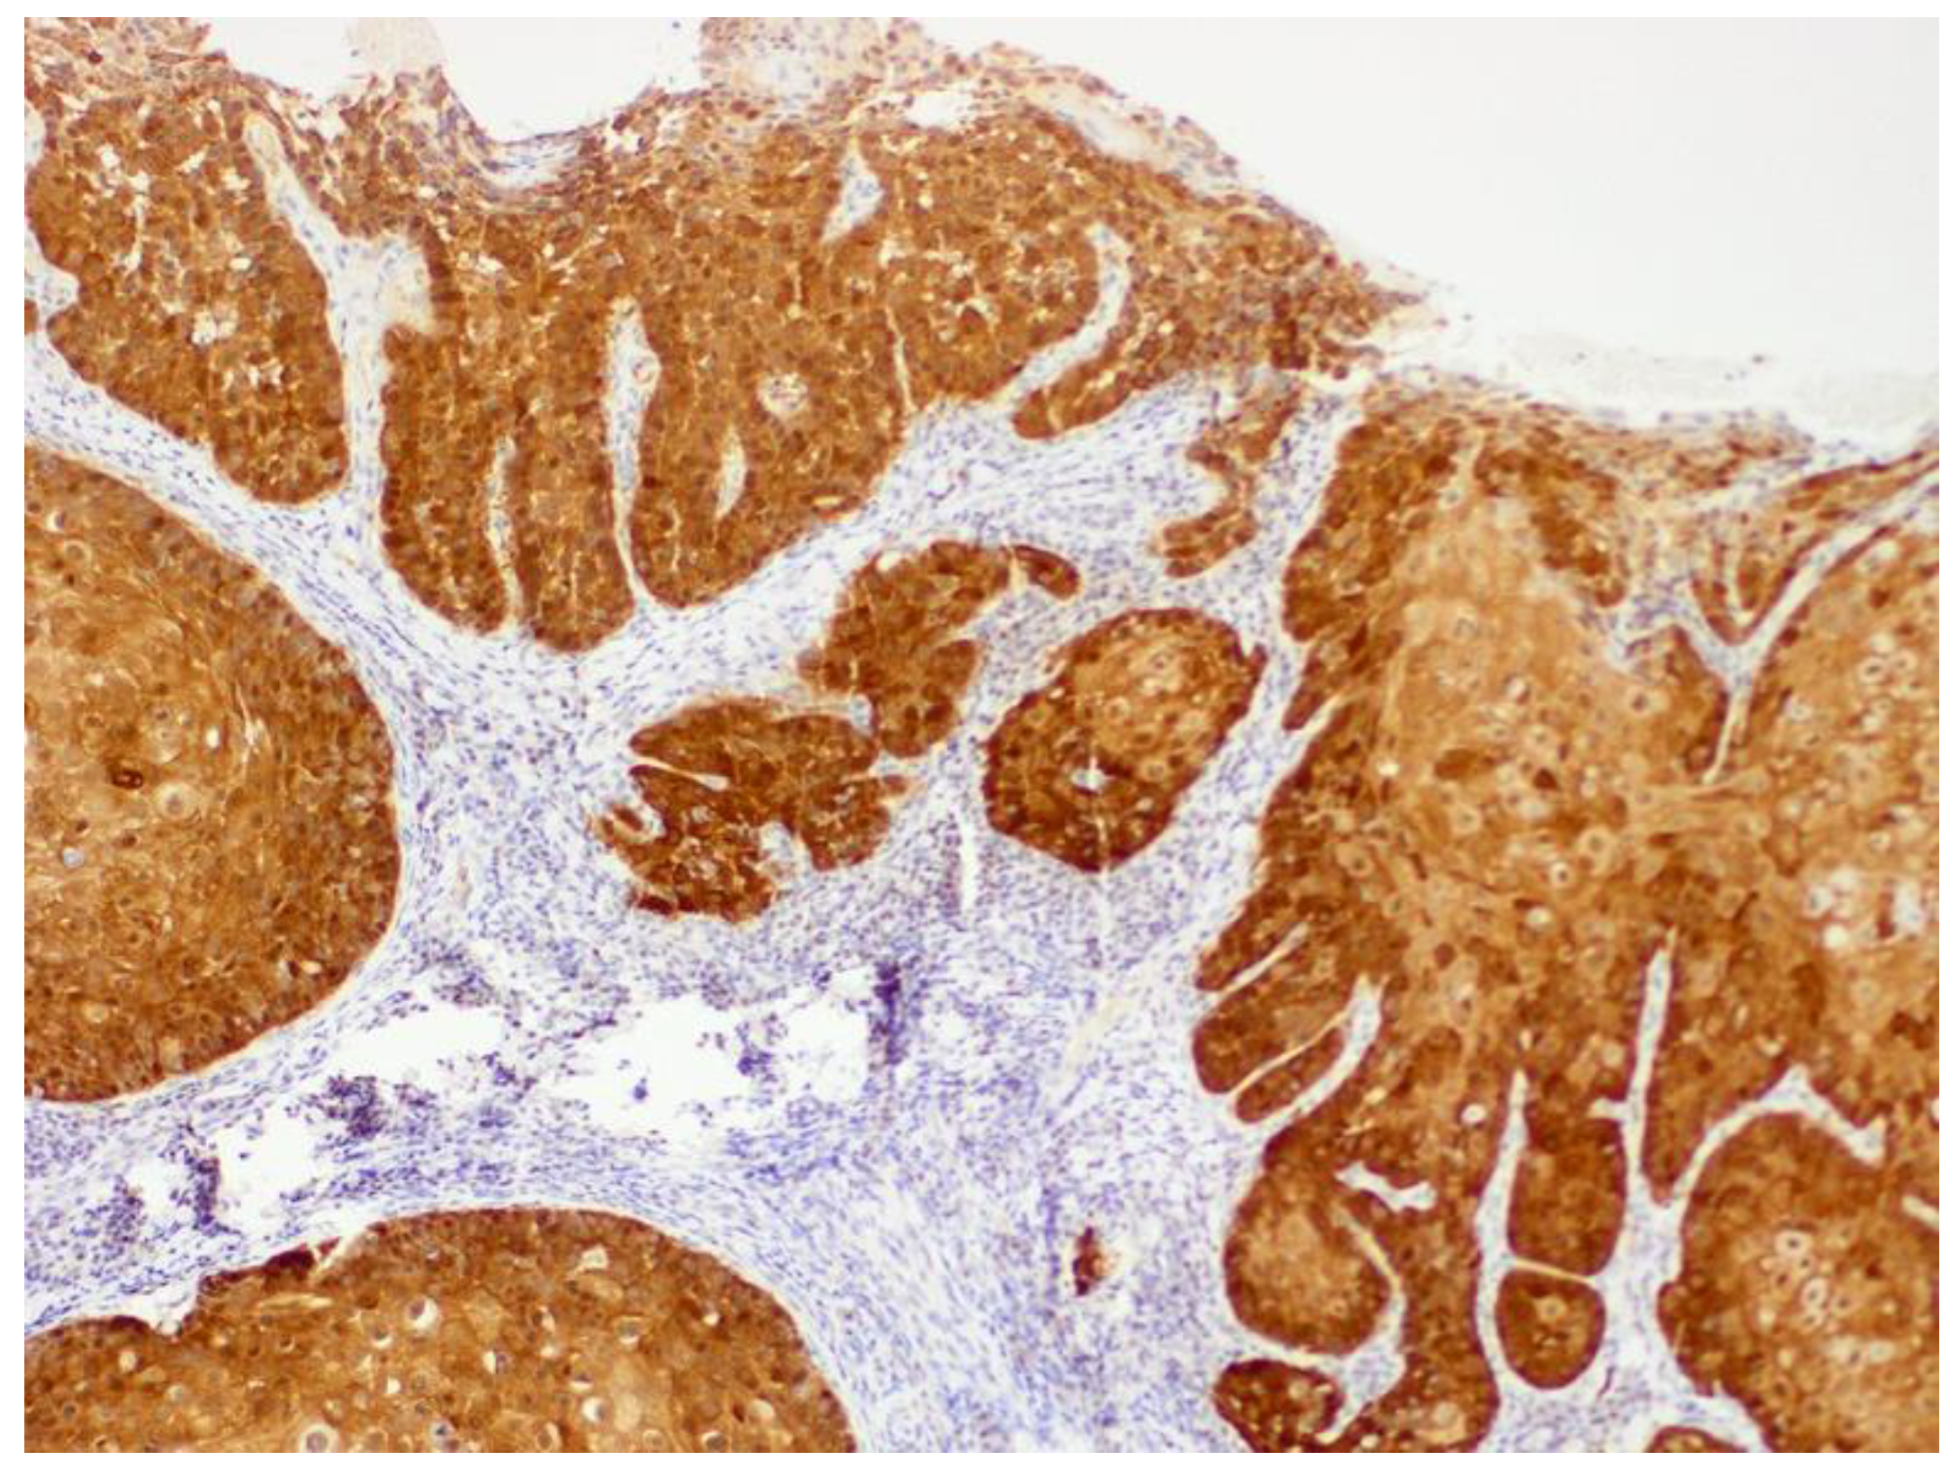
Pathogens 13 01057 g013

Papillomaviruses and Papillomaviral Disease in Dogs and Cats: A Comprehensive Review
Abstract
1. Introduction
2. Papillomaviral Life Cycle and Carcinogenesis
3. Immune Response to Papillomavirus Infection
4. Classification of Papillomavirus Types
5. Consequences and Diagnosis of Papillomavirus Infection
6. Papillomaviral Lesions in Dogs
6.1. Canine Viral Papillomas
6.2. Canine Viral Cutaneous Plaques
6.3. Papillomavirus-Associated Neoplasia in Dogs
7. Papillomaviral Lesions in Cats
7.1. Feline Viral Papillomas
7.2. Feline Viral Cutaneous Plaques
7.3. Papillomavirus-Associated Neoplasia in Cats
8. Vaccination to Prevent Papillomaviral Lesions in Dogs and Cats
9. Conclusions
Funding
Data Availability Statement
Acknowledgments
Conflicts of Interest
References
- de Martel, C.; Georges, D.; Bray, F.; Ferlay, J.; Clifford, G.M. Global burden of cancer attributable to infections in 2018: A worldwide incidence analysis. Lancet Glob. Health 2020, 8, e180–e190. [Google Scholar] [CrossRef] [PubMed]
- Eriksson, A.; Ahola, H.; Pettersson, U.; Moreno-Lopez, J. Genome of the European elk papillomavirus (EEPV). Virus Genes 1988, 1, 123–133. [Google Scholar] [CrossRef] [PubMed]
- Graham, S.V. The human papillomavirus replication cycle, and its links to cancer progression: A comprehensive review. Clin. Sci. 2017, 131, 2201–2221. [Google Scholar] [CrossRef]
- McBride, A.A. Human papillomaviruses: Diversity, infection and host interactions. Nat. Rev. Microbiol. 2022, 20, 95–108. [Google Scholar] [CrossRef] [PubMed]
- Doorbar, J. The papillomavirus life cycle. J. Clin. Virol. 2005, 32 (Suppl. S1), S7–S15. [Google Scholar] [CrossRef] [PubMed]
- Ozbun, M.A. Human papillomavirus type 31b infection of human keratinocytes and the onset of early transcription. J. Virol. 2002, 76, 11291–11300. [Google Scholar] [CrossRef] [PubMed]
- McBride, A.A. The papillomavirus E2 proteins. Virology 2013, 445, 57–79. [Google Scholar] [CrossRef]
- Klumpp, D.J.; Laimins, L.A. Differentiation-induced changes in promoter usage for transcripts encoding the human papillomavirus type 31 replication protein E1. Virology 1999, 257, 239–246. [Google Scholar] [CrossRef]
- Doorbar, J.; Quint, W.; Banks, L.; Bravo, I.G.; Stoler, M.; Broker, T.R.; Stanley, M.A. The biology and life-cycle of human papillomaviruses. Vaccine 2012, 30 (Suppl. S5), F55–F70. [Google Scholar] [CrossRef]
- Egawa, N.; Doorbar, J. The Low-Risk Papillomaviruses. Virus Res. 2017, 231, 119–127. [Google Scholar] [CrossRef]
- Munger, K.; White, E.A. What are the essential determinants of human papillomavirus carcinogenesis? mBio 2024, 15, e00462-24. [Google Scholar] [CrossRef] [PubMed]
- El-Naggar, A.K.; Westra, W.H. p16 expression as a surrogate marker for HPV-related oropharyngeal carcinoma: A guide for interpretative relevance and consistency. Head Neck 2012, 34, 459–461. [Google Scholar] [CrossRef] [PubMed]
- Moody, C.A.; Laimins, L.A. Human papillomavirus oncoproteins: Pathways to transformation. Nat. Rev. Cancer 2010, 10, 550–560. [Google Scholar] [CrossRef] [PubMed]
- Smola, S. Human Papillomaviruses and Skin Cancer. Adv. Exp. Med. Biol. 2020, 1268, 195–209. [Google Scholar]
- Küsters-Vandevelde, H.V.N.; de Koning, M.N.C.; Melchers, W.J.G.; Quint, W.G.V.; de Wilde, P.C.M.; de Jong, E.; van de Kerkhof, P.C.M.; Blokx, W.A.M. Expression of p14ARF, p16INK4a and p53 in relation to HPV in (pre-)malignant squamous skin tumours. J. Cell. Mol. Med. 2009, 13, 2148–2157. [Google Scholar] [CrossRef]
- Nagata, M.; Nanko, H.; Moriyama, A.; Washizu, T.; Ishida, T. Pigmented plaques associated with papillomavirus infection in dogs: Is this epidermodysplasia verruciformis? Vet. Dermatol. 1995, 6, 179–186. [Google Scholar] [CrossRef] [PubMed]
- Cruz-Gregorio, A.; Aranda-Rivera, A.K.; Pedraza-Chaverri, J. Pathological similarities in the development of papillomavirus-associated cancer in humans, dogs, and cats. Animals 2022, 12, 2390. [Google Scholar] [CrossRef]
- Luff, J.; Mader, M.; Rowland, P.; Britton, M.; Fass, J.; Yuan, H. Viral genome integration of canine papillomavirus 16. Papillomavirus Res. 2019, 7, 88–96. [Google Scholar] [CrossRef]
- Ito, S.; Chambers, J.K.; Sumi, A.; Omachi, T.; Haritani, M.; Nakayama, H.; Uchida, K. Genomic integration and expression of Felis catus papillomavirus type 2 oncogenes in feline Merkel cell carcinoma. Vet. Pathol. 2023, 60, 21–34. [Google Scholar] [CrossRef]
- Munday, J.S.; Aberdein, D. Loss of retinoblastoma protein, but not p53, is associated with the presence of papillomaviral DNA in feline viral plaques, Bowenoid in situ carcinomas, and squamous cell carcinomas. Vet. Pathol. 2012, 49, 538–545. [Google Scholar] [CrossRef]
- Munday, J.S.; French, A.F.; Peters-Kennedy, J.; Orbell, G.M.; Gwynne, K. Increased p16CDKN2A protein within feline cutaneous viral plaques, bowenoid in situ carcinomas, and a subset of invasive squamous cell carcinomas. Vet. Pathol. 2011, 48, 460–465. [Google Scholar] [CrossRef] [PubMed]
- Goldschmidt, M.H.; Kennedy, J.S.; Kennedy, D.R.; Yuan, H.; Holt, D.E.; Casal, M.L.; Traas, A.M.; Mauldin, E.A.; Moore, P.F.; Henthorn, P.S.; et al. Severe papillomavirus infection progressing to metastatic squamous cell carcinoma in bone marrow-transplanted X-linked SCID dogs. J. Virol. 2006, 80, 6621–6628. [Google Scholar] [CrossRef]
- Quinlan, S.; May, S.; Weeks, R.; Yuan, H.; Luff, J. Canine Papillomavirus 2 E6 Does Not Interfere With UVB-Induced Upregulation of p53 and p53-Regulated Genes. Front. Vet. Sci. 2021, 8, 570982. [Google Scholar] [CrossRef] [PubMed]
- Altamura, G.; Power, K.; Martano, M.; Degli Uberti, B.; Galiero, G.; De Luca, G.; Maiolino, P.; Borzacchiello, G. Felis catus papillomavirus type-2 E6 binds to E6AP, promotes E6AP/p53 binding and enhances p53 proteasomal degradation. Sci. Rep. 2018, 8, 17529. [Google Scholar] [CrossRef] [PubMed]
- Ito, S.; Chambers, J.K.; Sumi, A.; Yamashita-Kawanishi, N.; Omachi, T.; Haga, T.; Nakayama, H.; Uchida, K. Involvement of Felis catus papillomavirus type 2 in the tumorigenesis of feline Merkel cell carcinoma. Vet. Pathol. 2022, 59, 63–74. [Google Scholar] [CrossRef] [PubMed]
- Altamura, G.; Martano, M.; Licenziato, L.; Maiolino, P.; Borzacchiello, G. Telomerase Reverse Transcriptase (TERT) Expression, Telomerase Activity, and Expression of Matrix Metalloproteinases (MMP)-1/-2/-9 in Feline Oral Squamous Cell Carcinoma Cell Lines Associated with Felis catus Papillomavirus Type-2 Infection. Front. Vet. Sci. 2020, 7, 148. [Google Scholar] [CrossRef] [PubMed]
- Munday, J.S.; Benfell, M.W.; French, A.; Orbell, G.M.; Thomson, N. Bowenoid in situ carcinomas in two Devon Rex cats: Evidence of unusually aggressive neoplasm behaviour in this breed and detection of papillomaviral gene expression in primary and metastatic lesions. Vet. Dermatol. 2016, 27, 215-e55. [Google Scholar] [CrossRef] [PubMed]
- Ravens, P.A.; Vogelnest, L.J.; Tong, L.J.; Demos, L.E.; Bennett, M.D. Papillomavirus-associated multicentric squamous cell carcinoma in situ in a cat: An unusually extensive and progressive case with subsequent metastasis. Vet. Dermatol. 2013, 24, 642-e162. [Google Scholar] [CrossRef]
- Munday, J.S.; Kiupel, M. Papillomavirus-associated cutaneous neoplasia in mammals. Vet. Pathol. 2010, 47, 254–264. [Google Scholar] [CrossRef]
- Ghim, S.; Newsome, J.; Bell, J.; Sundberg, J.P.; Schlegel, R.; Jenson, A.B. Spontaneously regressing oral papillomas induce systemic antibodies that neutralize canine oral papillomavirus. Exp. Mol. Pathol. 2000, 68, 147–151. [Google Scholar] [CrossRef]
- Suzich, J.A.; Ghim, S.J.; Palmer-Hill, F.J.; White, W.I.; Tamura, J.K.; Bell, J.A.; Newsome, J.A.; Jenson, A.B.; Schlegel, R. Systemic immunization with papillomavirus L1 protein completely prevents the development of viral mucosal papillomas. Proc. Nat. Acad. Sci. USA 1995, 92, 11553–11557. [Google Scholar] [CrossRef]
- Nicholls, P.K.; Klaunberg, B.A.; Moore, R.A.; Santos, E.B.; Parry, N.R.; Gough, G.W.; Stanley, M.A. Naturally occurring, nonregressing canine oral papillomavirus infection: Host immunity, virus characterization, and experimental infection. Virology 1999, 265, 365–374. [Google Scholar] [CrossRef]
- Nicholls, P.K.; Moore, P.F.; Anderson, D.M.; Moore, R.A.; Parry, N.R.; Gough, G.W.; Stanley, M.A. Regression of canine oral papillomas is associated with infiltration of CD4+ and CD8+ lymphocytes. Virology 2001, 283, 31–39. [Google Scholar] [CrossRef] [PubMed]
- Sancak, A.; Favrot, C.; Geisseler, M.D.; Muller, M.; Lange, C.E. Antibody titres against canine papillomavirus 1 peak around clinical regression in naturally occurring oral papillomatosis. Vet. Dermatol. 2015, 26, 57-e20. [Google Scholar] [CrossRef] [PubMed]
- Munday, J.S.; Knight, C.G.; Luff, J.A. Papillomaviral skin diseases of humans, dogs, cats and horses: A comparative review. Part 2: Pre-neoplastic and neoplastic diseases. Vet. J. 2022, 288, 105898. [Google Scholar] [CrossRef] [PubMed]
- Medeiros-Fonseca, B.; Faustino-Rocha, A.I.; Medeiros, R.; Oliveira, P.A.; Gil da Costa, R.M. Canine and feline papillomaviruses: An update. Front. Vet. Sci. 2023, 10, 1174673. [Google Scholar] [CrossRef] [PubMed]
- Quinlan, S.; May, S.; Weeks, R.; Yuan, H.; Luff, J.A. Abrogation of Constitutive and Induced Type I and Type III Interferons and Interferon-Stimulated Genes in Keratinocytes by Canine Papillomavirus 2 E6 and E7. Viruses 2020, 12, 677. [Google Scholar] [CrossRef] [PubMed]
- Bernard, H.U.; Burk, R.D.; Chen, Z.; van Doorslaer, K.; Hausen, H.; de Villiers, E.M. Classification of papillomaviruses (PVs) based on 189 PV types and proposal of taxonomic amendments. Virology 2010, 401, 70–79. [Google Scholar] [CrossRef]
- Delius, H.; Van Ranst, M.A.; Jenson, A.B.; zur Hausen, H.; Sundberg, J.P. Canine oral papillomavirus genomic sequence: A unique 1.5-kb intervening sequence between the E2 and L2 open reading frames. Virology 1994, 204, 447–452. [Google Scholar] [CrossRef]
- Lange, C.E.; Tobler, K.; Ackermann, M.; Panakova, L.; Thoday, K.L.; Favrot, C. Three novel canine papillomaviruses support taxonomic clade formation. J. Gen. Virol. 2009, 90, 2615–2621. [Google Scholar] [CrossRef]
- Lange, C.E.; Jennings, S.H.; Diallo, A.; Lyons, J. Canine papillomavirus types 1 and 2 in classical papillomas: High abundance, different morphological associations and frequent co-infections. Vet. J. 2019, 250, 1–5. [Google Scholar] [CrossRef] [PubMed]
- Munday, J.S.; Dunowska, M.; Laurie, R.E.; Hills, S. Genomic characterisation of canine papillomavirus type 17, a possible rare cause of canine oral squamous cell carcinoma. Vet. Microbiol. 2016, 182, 135–140. [Google Scholar] [CrossRef] [PubMed]
- Luff, J.A.; Affolter, V.K.; Yeargan, B.; Moore, P.F. Detection of six novel papillomavirus sequences within canine pigmented plaques. J. Vet. Diagn. Investig. 2012, 24, 576–580. [Google Scholar] [CrossRef] [PubMed]
- Luff, J.; Rowland, P.; Mader, M.; Orr, C.; Yuan, H. Two canine papillomaviruses associated with metastatic squamous cell carcinoma in two related Basenji dogs. Vet. Pathol. 2016, 53, 1160–1163. [Google Scholar] [CrossRef] [PubMed]
- Munday, J.S.; Bond, S.D.; Piripi, S.; Soulsby, S.J.; Knox, M.A. Canis familiaris papillomavirus type 26: A novel papillomavirus of dogs and the first canine papillomavirus within the Omegapapillomavirus genus. Viruses 2024, 16, 595. [Google Scholar] [CrossRef]
- Sundberg, J.P.; Van Ranst, M.; Montali, R.; Homer, B.L.; Miller, W.H.; Rowland, P.H.; Scott, D.W.; England, J.J.; Dunstan, R.W.; Mikaelian, I.; et al. Feline papillomas and papillomaviruses. Vet. Pathol. 2000, 37, 1–10. [Google Scholar] [CrossRef]
- Munday, J.S.; Fairley, R.A.; Mills, H.; Kiupel, M.; Vaatstra, B.L. Oral papillomas associated with Felis catus papillomavirus type 1 in 2 domestic cats. Vet. Pathol. 2015, 52, 1187–1190. [Google Scholar] [CrossRef] [PubMed]
- Munday, J.S.; Peters-Kennedy, J. Consistent detection of Felis domesticus papillomavirus 2 DNA sequences within feline viral plaques. J. Vet. Diagn. Investig. 2010, 22, 946–949. [Google Scholar] [CrossRef]
- Munday, J.S.; Kiupel, M.; French, A.F.; Howe, L. Amplification of papillomaviral DNA sequences from a high proportion of feline cutaneous in situ and invasive squamous cell carcinomas using a nested polymerase chain reaction. Vet. Dermatol. 2008, 19, 259–263. [Google Scholar] [CrossRef]
- Munday, J.S.; Thomson, N.A.; Henderson, G.; Fairley, R.; Orbell, G.M. Identification of Felis catus papillomavirus 3 in skin neoplasms from four cats. J. Vet. Diagn. Investig. 2018, 30, 324–328. [Google Scholar] [CrossRef]
- Munday, J.S.; Dittmer, K.E.; Thomson, N.A.; Hills, S.F.; Laurie, R.E. Genomic characterisation of Felis catus papillomavirus type 5 with proposed classification within a new papillomavirus genus. Vet. Microbiol. 2017, 207, 50–55. [Google Scholar] [CrossRef] [PubMed]
- Yamashita-Kawanishi, N.; Gushino, Y.; Chang, C.Y.; Chang, H.W.; Chambers, J.K.; Uchida, K.; Haga, T. Full-genome characterization of a novel Felis catus papillomavirus 4 subtype identified in a cutaneous squamous cell carcinoma of a domestic cat. Virus Genes 2021, 57, 380–384. [Google Scholar] [CrossRef] [PubMed]
- Munday, J.S.; Gedye, K.; Knox, M.A.; Pfeffer, H.; Lin, X. Genetic characterisation of Felis catus papillomavirus type 7, a rare infection of cats that may be associated with skin cancer. Vet. Microbiol. 2023, 284, 109813. [Google Scholar] [CrossRef]
- Lange, C.E.; Zollinger, S.; Tobler, K.; Ackermann, M.; Favrot, C. Clinically healthy skin of dogs is a potential reservoir for canine papillomaviruses. J. Clin. Microbiol. 2011, 49, 707–709. [Google Scholar] [CrossRef] [PubMed]
- Thomson, N.A.; Dunowska, M.; Munday, J.S. The use of quantitative PCR to detect Felis catus papillomavirus type 2 DNA from a high proportion of queens and their kittens. Vet. Microbiol. 2015, 175, 211–217. [Google Scholar] [CrossRef]
- Munday, J.S.; Knight, C.G.; Luff, J.A. Papillomaviral skin diseases of humans, dogs, cats and horses: A comparative review. Part 1: Papillomavirus biology and hyperplastic lesions. Vet. J. 2022, 288, 105897. [Google Scholar] [CrossRef] [PubMed]
- Munday, J.S.; Thomson, N.; Dunowska, M.; Knight, C.G.; Laurie, R.E.; Hills, S. Genomic characterisation of the feline sarcoid-associated papillomavirus and proposed classification as Bos taurus papillomavirus type 14. Vet. Microbiol. 2015, 177, 289–295. [Google Scholar] [CrossRef]
- Munday, J.S.; Knight, C.G.; Howe, L. The same papillomavirus is present in feline sarcoids from North America and New Zealand but not in any non-sarcoid feline samples. J. Vet. Diagn. Investig. 2010, 22, 97–100. [Google Scholar] [CrossRef]
- Merchioratto, I.; Mucellini, C.I.; Lopes, T.R.R.; de Oliveira, P.S.B.; Silva Júnior, J.V.J.; Brum, M.C.S.; Weiblen, R.; Flores, E.F. Phylogenetic analysis of papillomaviruses in dogs from southern Brazil: Molecular epidemiology and investigation of mixed infections and spillover events. Braz. J. Microbiol. 2024, 55, 2025–2033. [Google Scholar] [CrossRef] [PubMed]
- Kim, D.; Dobromylskyj, M.J.; O’Neill, D.; Smith, K.C. Skin masses in dogs under one year of age. J. Small Anim. Pract. 2022, 63, 10–15. [Google Scholar] [CrossRef]
- Lane, H.E.; Weese, J.S.; Stull, J.W. Canine oral papillomavirus outbreak at a dog daycare facility. Can. Vet. J. 2017, 58, 747–749. [Google Scholar]
- Gould, A.P.; Coyner, K.S.; Trimmer, A.M.; Tater, K.; Rishniw, M. Canine pedal papilloma identification and management: A retrospective series of 44 cases. Vet. Dermatol. 2021, 32, 509-e141. [Google Scholar] [CrossRef]
- Resendes, A.R.; Trainor, K.E.; Bera, M.; Cheng, R.C.F.; Luff, J. Claw bed inverted squamous papilloma associated with canine papillomavirus type 2 in a dog. Vet. Dermatol. 2024, 35, 230–233. [Google Scholar] [CrossRef] [PubMed]
- Cullen, M.A.; Fentiman, K.E.; Shaw, G.C.; Rankin, A.J. Report of a self-resolving corneal viral papilloma in a dog. Can. Vet. J. 2023, 64, 123–126. [Google Scholar] [PubMed]
- Falk, E.; Lange, C.E.; Jennings, S.; Ferrer, L. Two cutaneous horns associated with canine papillomavirus type 1 infection in a pit bull dog. Vet. Dermatol. 2017, 28, 420–421. [Google Scholar] [CrossRef] [PubMed]
- Munday, J.S.; French, A.F.; MacNamara, A.R. The development of multiple cutaneous inverted papilloma following ovariohysterectomy in a dog. N. Z. Vet. J. 2010, 58, 168–171. [Google Scholar] [CrossRef] [PubMed]
- Orlandi, M.; Mazzei, M.; Vascellari, M.; Melchiotti, E.; Zanardello, C.; Verin, R.; Albanese, F.; Necci, F.; Pazzini, L.; Lazzarini, G.; et al. Localization and genotyping of canine papillomavirus in canine inverted papillomas. J. Vet. Diagn. Investig. 2021, 33, 1069–1078. [Google Scholar] [CrossRef] [PubMed]
- Le Net, J.L.; Orth, G.; Sundberg, J.P.; Cassonnet, P.; Poisson, L.; Masson, M.T.; George, C.; Longeart, L. Multiple pigmented cutaneous papules associated with a novel canine papillomavirus in an immunosuppressed dog. Vet. Pathol. 1997, 34, 8–14. [Google Scholar] [CrossRef]
- Munday, J.S.; Piripi, S.A.; Julian, A.; Martin, S.J. Long-term recurrent, yet nonprogressive, pedal viral papillomas in a dog. Vet. Dermatol. 2020, 31, 489-e128. [Google Scholar] [CrossRef]
- Richman, A.W.; Kirby, A.L.; Rosenkrantz, W.; Muse, R. Persistent papilloma treated with cryotherapy in three dogs. Vet. Dermatol. 2017, 28, 625-e154. [Google Scholar] [CrossRef] [PubMed]
- Yagci, B.B.; Ural, K.; Ocal, N.; Haydardedeoglu, A.E. Azithromycin therapy of papillomatosis in dogs: A prospective, randomized, double-blinded, placebo-controlled clinical trial. Vet. Dermatol. 2008, 19, 194–198. [Google Scholar] [CrossRef] [PubMed]
- Szczepanek, A.; Bertran, J.; Shiomitsu, K.; Thorsen, L.; Gutti, J.R.; Santoro, D.; Takada, M. Successful definitive radiation treatment of refractory canine oral papillomatosis. Vet. Radiol. Ultrasound 2024, 65, 507–512. [Google Scholar] [CrossRef] [PubMed]
- Kuntsi-Vaattovaara, H.; Verstraete, F.J.; Newsome, J.T.; Yuan, H. Resolution of persistent oral papillomatosis in a dog after treatment with a recombinant canine oral papillomavirus vaccine. Vet. Comp. Oncol. 2003, 1, 57–63. [Google Scholar] [CrossRef] [PubMed]
- Gilson, R.; Nugent, D.; Bennett, K.; Doré, C.J.; Murray, M.L.; Meadows, J.; Haddow, L.J.; Lacey, C.; Sandmann, F.; Jit, M.; et al. Imiquimod versus podophyllotoxin, with and without human papillomavirus vaccine, for anogenital warts: The HIPvac factorial RCT. Health Technol. Assess 2020, 24, 1–86. [Google Scholar] [CrossRef] [PubMed]
- Miller, R.L.; Gerster, J.F.; Owens, M.L.; Slade, H.B.; Tomai, M.a. Imiquimod applied topically: A novel immune response modifier and new class of drug. Int. J. Immunopharmacol. 1999, 21, 1–14. [Google Scholar] [CrossRef]
- Raj, P.A.A.; Pavulraj, S.; Kumar, M.A.; Sangeetha, S.; Shanmugapriya, R.; Sabithabanu, S. Therapeutic evaluation of homeopathic treatment for canine oral papillomatosis. Vet. World 2020, 13, 206–213. [Google Scholar] [CrossRef]
- Regalado Ibarra, A.M.; Legendre, L.; Munday, J.S. Malignant transformation of a canine papillomavirus type 1-induced persistent oral papilloma in a 3-year-old dog. J. Vet. Dent. 2018, 35, 79–95. [Google Scholar] [CrossRef] [PubMed]
- Beziat, V.; Casanova, J.L.; Jouanguy, E. Human genetic and immunological dissection of papillomavirus-driven diseases: New insights into their pathogenesis. Curr. Opin Virol. 2021, 51, 9–15. [Google Scholar] [CrossRef]
- Munday, J.S.; Thomson, N.A.; Luff, J.A. Papillomaviruses in dogs and cats. Vet. J. 2017, 225, 23–31. [Google Scholar] [CrossRef]
- Stokking, L.B.; Ehrhart, E.J.; Lichtensteiger, C.A.; Campbell, K.L. Pigmented epidermal plaques in three dogs. J. Am. Anim. Hosp. Assoc. 2004, 40, 411–417. [Google Scholar] [CrossRef]
- Hansen, N.; Nicholas, N.; Pack, G.; Mackie, J.T.; Shipstone, M.; Munday, J.S.; Reddell, P.; Orbell, G.; Malik, R. Progressive cutaneous viral pigmented plaques in three Hungarian Vizslas and the response of lesions to topical tigilanol tiglate gel. Vet. Med. Sci. 2018, 4, 53–62. [Google Scholar] [CrossRef] [PubMed]
- De Lucia, M.; Denti, D.; Werlen, N.A.; Ramsauer, A.S. Canine pigmented viral plaques associated with application of potent topical glucocorticoids. Vet. Dermatol. 2024. Epub ahead of printing. [Google Scholar] [CrossRef] [PubMed]
- Orlandi, M.; Mazzei, M.; Albanese, F.; Pazzini, L.; Mei, M.; Lazzarini, G.; Forzan, M.; Massaro, M.; Vascellari, M.; Abramo, F. Clinical, histopathological, and molecular characterization of canine pigmented viral plaques. Vet. Pathol. 2023, 60, 857–864. [Google Scholar] [CrossRef] [PubMed]
- Munday, J.S.; Lam, A.T.H.; Sakai, M. Extensive progressive pigmented viral plaques in a Chihuahua dog. Vet. Dermatol. 2022, 33, 252–254. [Google Scholar] [CrossRef] [PubMed]
- Gross, T.L.; Ihrke, P.J.; Walder, E.J.; Affolter, V.K. Skin Diseases of the Dog and Cat: Clinical and Histopathologic Diagnosis, 2nd ed.; Blackwell Science: Oxford, UK, 2005; pp. 571–574. [Google Scholar]
- Munday, J.S.; Orbell, G.; Robinson, L. Detection of a novel papillomaviral sequence in viral plaques confined to the pinna of a dog. Vet. Dermatol. 2023, 34, 367–370. [Google Scholar] [CrossRef]
- Alves, C.; Weber, M.N.; Guimarães, L.L.B.; Cibulski, S.P.; da Silva, F.R.C.; Daudt, C.; Budaszewski, R.F.; Silva, M.S.; Mayer, F.Q.; Bianchi, R.M.; et al. Canine papillomavirus type 16 associated to squamous cell carcinoma in a dog: Virological and pathological findings. Braz. J. Microbiol. 2020, 51, 2087–2094. [Google Scholar] [CrossRef]
- Knight, E.C.; Munday, J.S.; Stone, B.M.; Shipstone, M.A. Carbon dioxide laser treatment of extensive pigmented viral plaque lesions in a golden retriever dog. Vet. Dermatol. 2016, 27, 442-e117. [Google Scholar] [CrossRef]
- Munday, J.S.; O’Connor, K.I.; Smits, B. Development of multiple pigmented viral plaques and squamous cell carcinomas in a dog infected by a novel papillomavirus. Vet. Dermatol. 2011, 22, 104–110. [Google Scholar] [CrossRef] [PubMed]
- Munday, J.S.; Tucker, R.S.; Kiupel, M.; Harvey, C.J. Multiple oral carcinomas associated with a novel papillomavirus in a dog. J. Vet. Diagn. Investig. 2015, 27, 221–225. [Google Scholar] [CrossRef]
- Zaugg, N.; Nespeca, G.; Hauser, B.; Ackermann, M.; Favrot, C. Detection of novel papillomaviruses in canine mucosal, cutaneous and in situ squamous cell carcinomas. Vet. Dermatol. 2005, 16, 290–298. [Google Scholar] [CrossRef]
- Waropastrakul, S.; Munday, J.S.; French, A.F. Infrequent detection of papillomaviral DNA within canine cutaneous squamous cell carcinomas, haemangiosarcomas and healthy skin on the ventrum of dogs. Vet. Dermatol. 2012, 23, 197–201. [Google Scholar] [CrossRef] [PubMed]
- Teifke, J.P.; Lohr, C.V.; Shirasawa, H. Detection of canine oral papillomavirus-DNA in canine oral squamous cell carcinomas and p53 overexpressing skin papillomas of the dog using the polymerase chain reaction and non-radioactive in situ hybridization. Vet. Microbiol. 1998, 60, 119–130. [Google Scholar] [CrossRef] [PubMed]
- Munday, J.S.; French, A.; Harvey, C.J. Molecular and immunohistochemical studies do not support a role for papillomaviruses in canine oral squamous cell carcinoma development. Vet. J. 2015, 204, 223–225. [Google Scholar] [CrossRef] [PubMed]
- Porcellato, I.; Brachelente, C.; Guelfi, G.; Reginato, A.; Sforna, M.; Bongiovanni, L.; Mechelli, L. A retrospective investigation on canine papillomavirus 1 (CPV1) in oral oncogenesis reveals dogs are not a suitable animal model for high-risk HPV-induced oral cancer. PLoS ONE 2014, 9, e112833. [Google Scholar] [CrossRef] [PubMed]
- Orbell, H.L.; Munday, J.S.; Orbell, G.M.B.; Griffin, C.E. Development of multiple cutaneous and follicular neoplasms associated with canine papillomavirus type 3 in a dog. Vet. Dermatol. 2020, 31, 401–403. [Google Scholar] [CrossRef]
- de Carvalho, J.P.; Carrilho, M.C.; Dos Anjos, D.S.; Hernandez, C.D.; Sichero, L.; Dagli, M.L.Z. Unraveling the risk factors and etiology of the canine oral mucosal melanoma: Results of an epidemiological questionnaire, oral microbiome analysis and investigation of papillomavirus infection. Cancers 2022, 14, 3397. [Google Scholar] [CrossRef]
- Munday, J.S.; Waropastrakul, S.; Gibson, I.; French, A.F. Papillomaviral DNA sequences are not amplifiable from canine subungual squamous cell carcinomas. N. Z. Vet. J. 2013, 61, 234–236. [Google Scholar] [CrossRef]
- Munday, J.S.; MacLachlan, C.B.; Perrott, M.R.; Aberdein, D. Papillomavirus DNA is not amplifiable from bladder, lung, or mammary gland cancers in dogs or cats. Animals 2019, 9, 668. [Google Scholar] [CrossRef]
- Carpenter, J.L.; Kreider, J.W.; Alroy, J.; Schmidt, G.M. Cutaneous xanthogranuloma and viral papilloma on an eyelid of a cat. Vet. Dermatol. 1992, 3, 187–190. [Google Scholar] [CrossRef]
- Munday, J.S.; Hanlon, E.M.; Howe, L.; Squires, R.A.; French, A.F. Feline cutaneous viral papilloma associated with human papillomavirus type 9. Vet. Pathol. 2007, 44, 924–927. [Google Scholar] [CrossRef]
- Munday, J.S.; Julian, A. Exophytic cutaneous papilloma associated with a novel papillomavirus sequence in a cat. J. Vet. Diagn. Investig. 2022, 34, 902–904. [Google Scholar] [CrossRef] [PubMed]
- Munday, J.S.; Thomson, N.A. Papillomaviruses in Domestic Cats. Viruses 2021, 13, 1664. [Google Scholar] [CrossRef] [PubMed]
- Wilhelm, S.; Degorce-Rubiales, F.; Godson, D.; Favrot, C. Clinical, histological and immunohistochemical study of feline viral plaques and bowenoid in situ carcinomas. Vet. Dermatol. 2006, 17, 424–431. [Google Scholar] [CrossRef] [PubMed]
- Gill, V.L.; Bergman, P.J.; Baer, K.E.; Craft, D.; Leung, C. Use of imiquimod 5% cream (Aldara) in cats with multicentric squamous cell carcinoma in situ: 12 cases (2002–2005). Vet. Comp. Oncol. 2008, 6, 55–64. [Google Scholar] [CrossRef]
- Nespeca, G.; Grest, P.; Rosenkrantz, W.S.; Ackermann, M.; Favrot, C. Detection of novel papillomaviruslike sequences in paraffin-embedded specimens of invasive and in situ squamous cell carcinomas from cats. Am. J. Vet. Res. 2006, 67, 2036–2041. [Google Scholar] [CrossRef]
- Munday, J.S.; Gibson, I.; French, A.F. Papillomaviral DNA and increased p16CDKN2A protein are frequently present within feline cutaneous squamous cell carcinomas in ultraviolet-protected skin. Vet. Dermatol. 2011, 22, 360–366. [Google Scholar] [CrossRef]
- Yamashita-Kawanishi, N.; Sawanobori, R.; Matsumiya, K.; Uema, A.; Chambers, J.K.; Uchida, K.; Shimakura, H.; Tsuzuki, M.; Chang, C.Y.; Chang, H.W.; et al. Detection of felis catus papillomavirus type 3 and 4 DNA from squamous cell carcinoma cases of cats in Japan. J. Vet. Med. Sci. 2018, 80, 1236–1240. [Google Scholar] [CrossRef]
- Thomson, N.A.; Munday, J.S.; Dittmer, K.E. Frequent detection of transcriptionally active Felis catus papillomavirus 2 in feline cutaneous squamous cell carcinomas. J. Gen. Virol. 2016, 97, 1189–1197. [Google Scholar] [CrossRef]
- Altamura, G.; Corteggio, A.; Pacini, L.; Conte, A.; Pierantoni, G.M.; Tommasino, M.; Accardi, R.; Borzacchiello, G. Transforming properties of Felis catus papillomavirus type 2 E6 and E7 putative oncogenes in vitro and their transcriptional activity in feline squamous cell carcinoma in vivo. Virology 2016, 496, 1–8. [Google Scholar] [CrossRef]
- Hoggard, N.; Munday, J.S.; Luff, J. Localization of Felis catus papillomavirus type 2 E6 and E7 RNA in feline cutaneous squamous cell carcinoma. Vet. Pathol. 2018, 55, 409–416. [Google Scholar] [CrossRef]
- Thomson, N.A.; Howe, L.; Weidgraaf, K.; Thomas, D.G.; Young, V.; Ward, V.K.; Munday, J.S. Felis catus papillomavirus type 2 virus-like particle vaccine is safe and immunogenic but does not reduce FcaPV-2 viral loads in adult cats. Vet. Immunol. Immunopathol. 2019, 213, 109888. [Google Scholar] [CrossRef] [PubMed]
- Chambers, J.K.; Ito, S.; Uchida, K. Feline papillomavirus-associated Merkel cell carcinoma: A comparative review with human Merkel cell carcinoma. J. Vet. Med. Sci. 2023, 85, 1195–1209. [Google Scholar] [CrossRef] [PubMed]
- Munday, J.S.; Hardcastle, M.; Dally, N. In situ squamous cell carcinoma of the gingiva and nictitating membrane associated with Felis catus papillomavirus type 3 in a cat. Vet. Pathol. 2022, 59, 463–466. [Google Scholar] [CrossRef] [PubMed]
- Munday, J.S.; Howe, L.; French, A.; Squires, R.A.; Sugiarto, H. Detection of papillomaviral DNA sequences in a feline oral squamous cell carcinoma. Res. Vet. Sci. 2009, 86, 359–361. [Google Scholar] [CrossRef] [PubMed]
- Munday, J.S.; French, A.F. Felis catus papillomavirus types 1 and 4 are rarely present in neoplastic and inflammatory oral lesions of cats. Res. Vet. Sci. 2015, 100, 220–222. [Google Scholar] [CrossRef]
- Munday, J.S.; Knight, C.G.; French, A.F. Evaluation of feline oral squamous cell carcinomas for p16CDKN2A protein immunoreactivity and the presence of papillomaviral DNA. Res. Vet. Sci. 2011, 90, 280–283. [Google Scholar] [CrossRef] [PubMed]
- O’Neill, S.H.; Newkirk, K.M.; Anis, E.A.; Brahmbhatt, R.; Frank, L.A.; Kania, S.A. Detection of human papillomavirus DNA in feline premalignant and invasive squamous cell carcinoma. Vet. Dermatol. 2011, 22, 68–74. [Google Scholar] [CrossRef] [PubMed]
- Chu, S.; Wylie, T.N.; Wylie, K.M.; Johnson, G.C.; Skidmore, Z.L.; Fleer, M.; Griffith, O.L.; Bryan, J.N. A virome sequencing approach to feline oral squamous cell carcinoma to evaluate viral causative factors. Vet. Microbiol. 2020, 240, 108491. [Google Scholar] [CrossRef] [PubMed]
- Altamura, G.; Cardeti, G.; Cersini, A.; Eleni, C.; Cocumelli, C.; Bartolomé del Pino, L.E.; Razzuoli, E.; Martano, M.; Maiolino, P.; Borzacchiello, G. Detection of Felis catus papillomavirus type-2 DNA and viral gene expression suggest active infection in feline oral squamous cell carcinoma. Vet. Comp. Oncol. 2020, 18, 494–501. [Google Scholar] [CrossRef] [PubMed]
- Yamashita-Kawanishi, N.; Chang, C.Y.; Chambers, J.K.; Uchida, K.; Sugiura, K.; Kukimoto, I.; Chang, H.W.; Haga, T. Comparison of prevalence of Felis catus papillomavirus type 2 in squamous cell carcinomas in cats between Taiwan and Japan. J. Vet. Med. Sci. 2021, 83, 1229–1233. [Google Scholar] [CrossRef] [PubMed]
- Altamura, G.; Cuccaro, B.; Eleni, C.; Strohmayer, C.; Brandt, S.; Borzacchiello, G. Investigation of multiple Felis catus papillomavirus types (-1/-2/-3/-4/-5/-6) DNAs in feline oral squamous cell carcinoma: A multicentric study. J. Vet. Med. Sci. 2022, 84, 881–884. [Google Scholar] [CrossRef]
- Nasry, W.H.S.; Jones, K.; Rodriguez-Lecompte, J.C.; Tesch, M.; Martin, C.K. Expression of mPGES1 and p16 in feline and human oral squamous cell carcinoma: A comparative oncology approach. Vet. Comp. Oncol. 2024, 22, 204–216. [Google Scholar] [CrossRef] [PubMed]
- Wood, C.J.; Selmic, L.E.; Schlag, A.N.; Bacmeister, C.; Séguin, B.; Culp, W.T.N.; Ayres, S.A.; Sumner, J.P.; Byer, B.; Mayer, U.K.; et al. Biological behaviour and clinical outcome in 42 cats with sarcoids (cutaneous fibropapillomas). Vet. Comp. Oncol. 2020, 18, 699–705. [Google Scholar] [CrossRef] [PubMed]
- Schulman, F.Y.; Krafft, A.E.; Janczewski, T. Feline cutaneous fibropapillomas: Clinicopathologic findings and association with papillomavirus infection. Vet. Pathol. 2001, 38, 291–296. [Google Scholar] [CrossRef] [PubMed]
- Teifke, J.P.; Kidney, B.A.; Lohr, C.V.; Yager, J.A. Detection of papillomavirus-DNA in mesenchymal tumour cells and not in the hyperplastic epithelium of feline sarcoids. Vet. Dermatol. 2003, 14, 47–56. [Google Scholar] [CrossRef] [PubMed]
- Pitisuttithum, P.; Velicer, C.; Luxembourg, A. 9-Valent HPV vaccine for cancers, pre-cancers and genital warts related to HPV. Exp. Rev. Vaccines 2015, 14, 1405–1419. [Google Scholar] [CrossRef]
- Kreider, J.W. Studies on the Mechanism Responsible for the Spontaneous Regression of the Shope Rabbit Papilloma. Cancer Res. 1963, 23, 1593–1599. [Google Scholar]

| Species | Papillomavirus Genus | Example Types | Associated Lesion |
|---|---|---|---|
| Dog | Lambdapapillomavirus | CPV1, 6 | Oral and cutaneous viral papilloma [39,40] |
| Taupapillomavirus | CPV2, 7 | Cutaneous viral papilloma [40,41] | |
| CPV17 | Oral SCC [42] | ||
| Chipapillomavirus | CPV3, 4, 16 | Cutaneous viral plaques [43] Cutaneous SCC [44] | |
| Omegapapillomavirus | CPV26 | Co-infection in oral viral papilloma [45] | |
| Cat | Lambdapapillomavirus | FcaPV1 | Oral and cutaneous viral papilloma [46,47] |
| Dyothetapapillomavirus | FcaPV2 | Cutaneous viral plaques [48] Cutaneous SCC [49] | |
| Taupapillomavirus | FcaPV3, 4, 5 | Cutaneous viral plaques [50,51] Cutaneous SCC [52] Cutaneous BCC [50] |
Disclaimer/Publisher’s Note: The statements, opinions and data contained in all publications are solely those of the individual author(s) and contributor(s) and not of MDPI and/or the editor(s). MDPI and/or the editor(s) disclaim responsibility for any injury to people or property resulting from any ideas, methods, instructions or products referred to in the content. |
© 2024 by the authors. Licensee MDPI, Basel, Switzerland. This article is an open access article distributed under the terms and conditions of the Creative Commons Attribution (CC BY) license (https://creativecommons.org/licenses/by/4.0/).
Share and Cite
Munday, J.S.; Knight, C.G. Papillomaviruses and Papillomaviral Disease in Dogs and Cats: A Comprehensive Review. Pathogens 2024, 13, 1057. https://doi.org/10.3390/pathogens13121057
Munday JS, Knight CG. Papillomaviruses and Papillomaviral Disease in Dogs and Cats: A Comprehensive Review. Pathogens. 2024; 13(12):1057. https://doi.org/10.3390/pathogens13121057
Chicago/Turabian StyleMunday, John S., and Cameron G. Knight. 2024. "Papillomaviruses and Papillomaviral Disease in Dogs and Cats: A Comprehensive Review" Pathogens 13, no. 12: 1057. https://doi.org/10.3390/pathogens13121057
APA StyleMunday, J. S., & Knight, C. G. (2024). Papillomaviruses and Papillomaviral Disease in Dogs and Cats: A Comprehensive Review. Pathogens, 13(12), 1057. https://doi.org/10.3390/pathogens13121057

